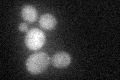
YLR405W
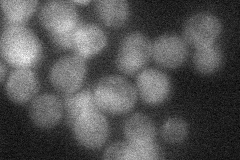
YLR405W
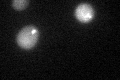
YLR405W

View description
Dihydrouridine synthase, member of a widespread family of conserved proteins including Smm1p, Dus1p, and Dus3p
Localization:
Intensity:
Fold change:
Significance:
-
C’ GFP library in SD
cytosol29.63 -
N' NOP1pr-GFP in SD

cytosol56.1989 -
N' TEF2pr-mCherry in SD

cytosol57.4247 -
N' NATIVEpr-GFP in SD
cytosol27.4558 -
N' TEF2pr-VC and Cyto-VN in SD

cytosol36.0425 -
C’ GFP library in SD+DTT
cytosolN/AN/ANo -
C’ GFP library in SD+H2O2

cytosol27.670.93No -
C’ GFP library in Starvation Media

cytosol33.711.13No -
C’ GFP library on the background of Pup2-DaMP

cytosol -
C’ GFP library on the background of CCT mutant

cytosol28.98370.978136No
